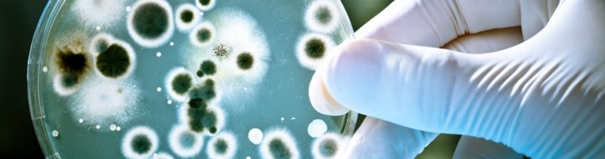
contamination

- MESURE ET PREVENTION DE LA POLLUTION DES CARBURANTS
Comment mesurer la pollution potentielle de son carburant ?
Sur quelle base peut on mesurer la pollution potentielle de son carburant ?
Les différents carburants présents dans les cuves de stockage des groupes secours ou production : diesels , HVO, Bio carburants GNR,... présentent tous et de manières différentes une durée de vie limitée.
Le diesel que nous achetons en Europe est un mélange de 93 % de diesel pétrochimique et de 7 % de biodiesel. Le biodiesel – ou FAME (Fatty Acid Methyl Ester) pour lui donner son nom technique – a été ajouté au diesel pétrochimique depuis 2011. Ce mélange de biodiesel contient moins de soufre que le diesel pétrochimique pur et réduit les émissions de CO2 jusqu’à 50 %. Cependant, la présence d’organismes biologiques dans le diesel fournit l’environnement idéal pour la contamination.
Cela apparait de manière plus flagrante quand le taux de bio diesel augmente jusqu'à devenir un problème sur le B100 en groupe secours.
La contamination par l’eau, l’ennemi du carburant peut commencer dès le remplissage avec des taux élevés dès le premier jour.
Types de contamination par le diesel
En vieillissant, le diesel souffre de 3 principaux types de contamination :
- Contamination de l’eau
- Eau dissoute : eau dissoute chimiquement ou absorbée dans l’eau et distribuée molécule par molécule
- Eau émulsionnée : de très petites gouttelettes d’eau sont en suspension dans le diesel
- Eau libre issue de la condensation : l’eau qui tombe de la condensation sur les parois de la cuve et s’accumule au fond du réservoir. Alors que l’eau dissoute peut affecter la stabilité du diesel, ce sont l’eau libre et l’eau émulsionnée qui posent le plus de problèmes. Non seulement il peut endommager le système de carburant et le moteur, mais il favorise surtout la croissance microbienne dans les systèmes de stockage de diesel.
- Croissance microbienne
- La croissance microbienne à l’intérieur d’un réservoir de stockage de diesel peut contenir jusqu’ à Jusqu’à 100 types différents de bactéries, de moisissures et de levures affectent les systèmes diesel non protégés.
- Bactéries : cellules uniques, généralement de 1 à 10 microns, avec un temps de génération de 20 à 30 minutes (c’est-à-dire le temps qu’il faut à la population pour doubler). Une cellule peut se multiplier en 2 millions en 7 heures par temps chaud. Les bactéries dégradent le diesel au fil du temps.
- Moisissure : un type de champignon avec de longs filaments multicellulaires. Il y a peu d’indications qu’ils dégradent le diesel, maisen raison de leurs longs brins, ils sont efficaces pour bloquer les filtres.
- Levure : un type de champignon différent à croissance lente. Les levures ont généralement une taille de 3 à 4 microns.
- Biofilms : structures complexes de microbes qui adhèrent aux parois du réservoir de stockage de diesel. Un biofilm commence à se former lorsque des microbes flottants atterrissent sur une surface et s’y fixent.
- Cette fixation est initialement réversible. S’ils ne sont pas enlevés, ils commencent à changer de structure et à s’attacher de manière irréversible. Ces microbes commencent alors à se diviser et à attirer d’autres microbes pour rejoindre la colonie. Les biofilms sont des structures complexes qui, avec le temps, peuvent atteindre quelques millimètres d’épaisseur et contenir des milliards de microbes. Parfois, peut-être à la suite de turbulences du réservoir, des morceaux de biofilm se détachent et bloquent les filtres à carburant. Les insectes dans les biofilms excrètent également de l’acide. Cet acide érodera un réservoir de carburant métallique. De nombreux réservoirs percés sont le résultat de la formation de biofilms.
La contamination n’a jamais été un problème grave. Mais depuis que le diesel a été mélangé au biodiesel , c’est devenu un problème.
- Contamination par les particules solides
- Asphaltines : plus ou moins présentes dans tous les carburants diesel pétrochimiques. Leur présence a tendance à augmenter avec les changements de température du diesel et l’oxydation. Ce sont des particules dures et cassantes qui ne sont pas solubles dans le diesel.
- Les asphaltines ont généralement une taille inférieure à 2 microns, ce qui les rend relativement inoffensifs pour un système d’injection de carburant. Cependant, ils peuvent s’agglomérer en particules plus grosses qui peuvent facilement bloquer les filtres du moteur ou endommager les injecteurs. Ces particules s’accumulent au fond d’un réservoir de carburant et peuvent former une boue huileuse qui est souvent confondue avec une contamination microbienne.
- Gommes et autres contaminants organiques : la stabilité à l’oxydation du biodiesel est inférieure à celle du diesel pétrochimique. Lorsque le carburant entre en contact avec l’oxygène, des réactions chimiques décomposent le diesel en peroxyde, en acides organiques et en sédiments gommeux. Ces substances molles et collantes peuvent coller aux filtres à carburant et aux composants du moteur et provoquer une érosion acide.
- Autres particules : telles que la poussière et le gravier de la route, la suie, la rouille du réservoir de carburant, les particules d’usure du moteur. Toutes les particules, quelle qu’en soit la source, peuvent causer de l’usure ou des dommages au système d’injection de carburant ou au moteur.
- Boues : on parle de « boues » dans les systèmes de carburant diesel et au fond des réservoirs de stockage. Il est souvent interprété comme étant l’un des contaminants ci-dessus. En réalité, une combinaison de ces contaminants fusionne pour former des boues.
